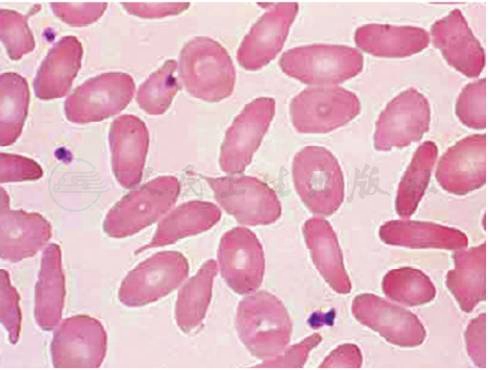

英文名称 :hereditary elliptocytosis
遗传性椭圆形红细胞增多症(hereditary elliptocytosis,HE)是一组以外周血红细胞呈椭圆形改变为特征的遗传性溶血性贫血。HE的发生率低于HS,但疟疾高发区其发病率较高。HE 常见的基因突变为:SPTA1、SPTB、EPB41。
HE有4种类型,即普通型HE、遗传性热变性异形红细胞增多症(hereditary pyropoikilocytosis,HPP)、球形细胞性 HE 和口形细胞性HE,后者又称东南亚卵圆形细胞增多症(Southeast Asian ovalocytosis,SAO)。其中普通型、球形细胞性HE及SAO为常染色体显性遗传,HPP为常染色体隐性遗传,因此多数病例可追溯到家族史。
普通型HE最常见。杂合子无症状,仅见外周血有椭圆形红细胞。纯合子或双重杂合子按贫血、黄疸、脾大的程度分轻、中、重3型,红细胞形态呈椭圆形和棒形(见图1),OF增高,脾切除可获得不同程度的改善。多数轻型和杂合子携带者无须治疗,但轻型HE在合并感染性脾大时也可诱发显著溶血。
图1外周血涂片示椭圆形红细胞
引自:实用内科学.第16版.ISBN:978-7-117-32482-3
球形细胞性HE具有HS和轻型HE双重特征,红细胞形态呈球状椭圆形和球形,OF增高,临床以中、重度多见,脾大明显,脾切除可获得明显改善。
HPP红细胞形态以小椭圆形、小球形、大量碎裂和不规则异形为特征,MCV明显下降,OF增高,临床中以中、重度多见,脾大明显,切脾可获得部分改善。
SAO在东南亚地区多见,分子病变累及带3蛋白,红细胞形态呈口形样卵圆形,中间有横嵴,红细胞膜僵硬,具有抵抗疟原虫的入侵,OF降低。纯合子可产生致死性溶血,因此仅见杂合子存活者,后者无症状无脾大,无须治疗。
HE的诊断主要依据外周血片椭圆形红细胞的增多,一般约占25%~90%。正常人椭圆形红细胞一般不超过5%~15%。须与其他引起椭圆形红细胞增多的疾病,如轻型珠蛋白生成障碍性贫血、缺铁性贫血、巨幼细胞贫血、骨髓纤维化、MDS、红细胞丙酮酸激酶缺乏症加以区别。
多数HE患者不需要治疗,贫血严重者可以脾切除,但增加血栓的风险,要严格掌握指征,其手术指征参见HS。溶血严重的患者要补充叶酸。经常做B超检查有无胆囊结石。



